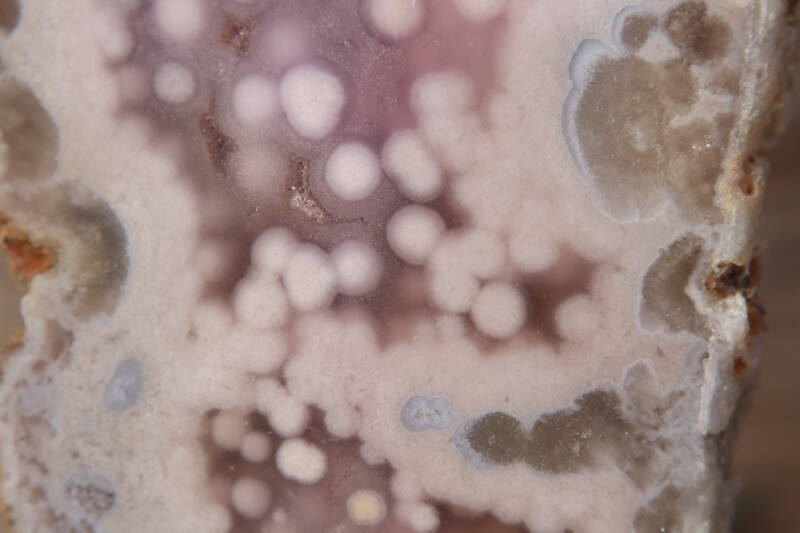

Roze amethist slab op standaard #0335
Roze Amethist Slab op Standaard #0335
Deze unieke Roze Amethist Slab weegt ongeveer 415 gram en heeft een totale hoogte van ongeveer 23,5 cm inclusief standaard. Het slab-vormige stuk toont de natuurlijke lagen en prachtige paarse tinten van roze amethist, een prachtig accent voor jouw interieur of spirituele ruimte.
Kenmerken:
-
Gewicht: circa 415 g
-
Hoogte incl. standaard: circa 23,5 cm
-
Materiaal: Roze Amethist slab
-
Presentatie: Stevige standaard voor mooi display
Spirituele werking:
Roze Amethist bevordert innerlijke rust, liefdevolle energie en emotioneel evenwicht. Ideaal voor meditatie, het versterken van positieve vibes en het creëren van harmonie in huis.
Waarom kiezen voor deze slab:
-
Unieke natuurlijke laagstructuur
-
Perfect als decoratief en spiritueel item
-
Met zorg geselecteerd en klaar om te stralen
Je ontvangt exact het product van de foto.
De kleuren zijn zo natuurgetrouw mogelijk vastgelegd, maar kunnen iets afwijken door scherminstellingen.